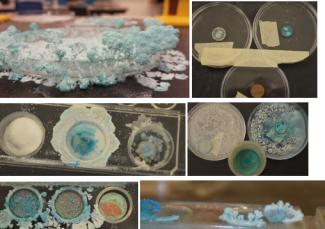
oxidize a copper penny science lab

Unlock Premium Teacher Access
🔓 Unlock Premium Teacher Access
Everything you need. One simple yearly plan.
Upgrade to Premium and get full access to all current and future content—designed to save you time, boost engagement, and support real classrooms.
✅ What’s included with Premium
-
Unlimited access to all content on the site
-
Exclusive teacher tools to plan, practice, and assess faster
-
Future Teachers Pay Teachers resources included
(All my current and upcoming TPT products will be added at no extra cost) -
New content added regularly—your subscription grows in value over time
💲 Simple, affordable pricing
$20 per year
Less than $2 a month for tools you can use all year long.
🎯 Who Premium is for
-
Classroom teachers who want ready-to-use resources
-
Teachers who like games, tools, and engagement
-
Anyone tired of buying the same types of resources over and over
Upgrade to Premium
In this lab students design and experiment that will oxidize a penny. The purpose of this lab besides demonstrating chemical weathering is to assess how well students are understanding the scientific method as well as their ability to think outside the box by taking content knowledge and applying it in a lab situation. I stand back from this lab to see how well students perform. Students will observe their pennies each day until their pennies are dry or for 3 or more days, depending on how they set up their design.
For more labs and resources for Earth Science, visit EarthScience.xyz